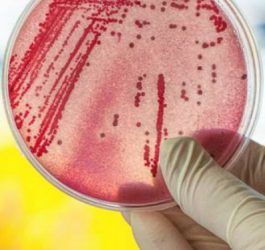

Libro blanco de los medicamentos biosimilares en España
Fuente: fgcasal.org Documento completo pdf Resumen IntroducciónUn medicamento biológico similar (o biosimilar)...
Read DetailsCuatro videos sobre Salud Comunitaria
Fuente: Rafa Cofiño, Jefe de Servicio de Evaluación de la Salud y Programas de la Dirección General de Salud Públic...
Read DetailsPiensa en el medioambiente durante las fiestas de fin de año
Fuente: cdc.gov Opta por lo sostenible cuando hagas compras, viajes, envíes tarjetas, decores y elijas regalos para...
Read DetailsLas infecciones por comer alimentos en mal estado se han doblado en los últimos cuatro años
La salmonelosis y las diarreas por campylobacterias son las dos enfermedades que pasan de animales a humanos por la...
Read Details¿La recuperación económica es feminista?
Bañez defiende que la recuperación económica es feminista.Fuente: elsaltodiario.com (Extracto) La ministra...
Read DetailsLos médicos de familia americanos se resisten a la medicalización
AAFP decide no aprobar la directriz de hipertensión de AHA / ACCFuente: AAFP.org Chris Crawford 12/12/2017 Tr...
Read DetailsOligopolio farmaceútico y colusión de intereses
Ni a la industria farmacéutica ni al gobierno del PP les gusta el libre mercado: prefieren el oligopolio y la colus...
Read DetailsSERMAS: Ley de Buen Gobierno y Gestión Sanitaria
Madrid aprueba la Ley que prohíbe designar gerentes de hospital 'a dedo'Fuente: redaccionmedica 15 de diciembre...
Read DetailsEl Parlamento italiano aprueba la Ley de Testamento Vital
El Parlamento italiano aprobó (14/12/2017) la ley del testamento vital, que permite a una persona indicar anticipad...
Read DetailsMedicamentos para todos: Patentes, genéricos y biosimilares
Numerosas organizaciones firman cartas en el marco de dos importantes procesos sobre Acceso a los Medicamentos e I+...
Read DetailsÉlites contra la Salud Pública
Trump, cambio climático y refugiados: élites contra la salud pública. Por Bruno Latour. Traducción de David Hammers...
Read DetailsLa creciente amenaza de bacterias multirresistentes
Las superbacterias aprovechan la contaminación ambiental para volverse invulnerables Fuente: eldiario.es Las super...
Read Details